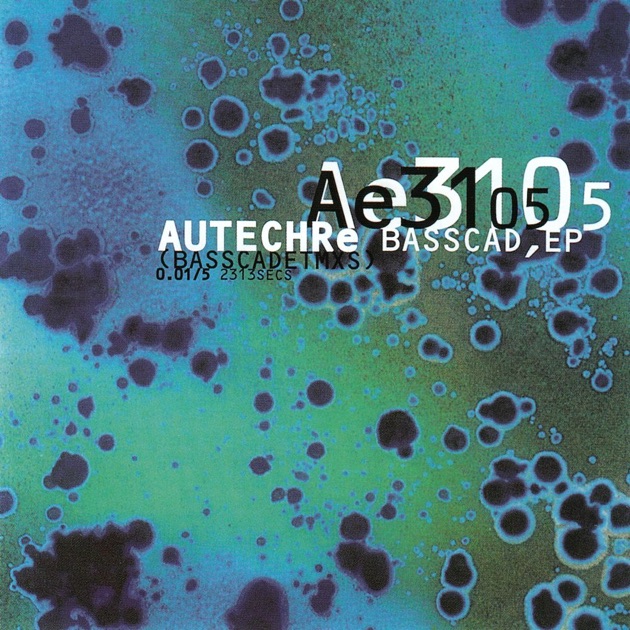
Beaucoup Fish (Remastered) - Album by Underworld - Apple Music

![オリジナル盤 Underworld Beaucoup Fish 2枚組 レコード Underworld – Beaucoup Fish – CD (Album), 1999 [r403807] | Discogs](https://i.discogs.com/U6xd_cQlj7K1O_ZGlvMo7uTKCQZ-1IkxiVCjz0dQPxU/rs:fit/g:sm/q:90/h:515/w:600/czM6Ly9kaXNjb2dz/LWRhdGFiYXNlLWlt/YWdlcy9SLTQwMzgw/Ny0xNDM4NTMzMDMw/LTk1MzYucG5n.jpeg)
マイストア
変更
お店で受け取る
(送料無料)
配送する
納期目安:
2026.02.18 19:43頃のお届け予定です。
決済方法が、クレジット、代金引換の場合に限ります。その他の決済方法の場合はこちらをご確認ください。
※土・日・祝日の注文の場合や在庫状況によって、商品のお届けにお時間をいただく場合がございます。
オリジナル盤 Underworld Beaucoup Fish 2枚組 レコード Underworld – Beaucoup Fish – CD (Album), 1999 [r403807] | Discogsの詳細情報
Underworld – Beaucoup Fish – CD (Album), 1999 [r403807] | Discogs。Underworld - Beaucoup Fish | Rough Trade - (2LP - Black, CD。Beaucoup Fish (Remastered) - Album by Underworld - Apple Music。【アーティストとアルバム】Underworldの「Beaucoup Fish」は、エレクトロニカとテクノの融合を特徴とした作品です。アーティストの独自のスタイルが際立つ一枚です。【トラック情報】収録されているトラックには「Cups」と「Push Upstairs」があり、それぞれの再生時間は11分45秒と4分34秒です。これらのトラックは、ダンスフロアでのプレイにも適しています。【デザインと仕様】ジャケットは青と紫のグラデーションが美しく、視覚的にも楽しませてくれます。また、2枚組のレコードで、コレクターにも魅力的なアイテムです。1999年のUKオリジナル盤。ジャケットには傷や角打ちがありますが盤面は綺麗です。昨今のレコードブームでオリジナル盤は中々見つからなくなってしまったと思います。是非この機会に手にして下さい。- アーティスト: Underworld- アルバム名: Beaucoup Fish- トラック名: Cups, Push Upstairs…- UKカタログ番号: JBD1005431- ジャケットデザイン: 青と紫のグラデーション- レコード 2枚組ノークレーム、ノーリターンでお願い致します#アンダーワールド#エレクトロニカ#ハウス#テクノ。Amazon.co.jp: Beaucoup Fish : Underworld: ミュージック。ブラインド・フェイス オール・ライト プレゼンスオブザロード レコード EP。Billie Eilish レコード red vinyl。洋楽 ´80年代 EPレコード 39点セット。洋楽レコード6枚セット。洋楽 CharlieParker:TheParkerJamSession。値引きしました ビートルズ LPレコードセット5タイトルまとめて。希少!12inch oasis Shakermaker アナログレコード LP。ウルトラマングレート「ゴーデス編」LD単品セル全3巻セット。洋楽 Li'l Louis - French Kiss (Kriece Remix)
ベストセラーランキングです
近くの売り場の商品
カスタマーレビュー
オススメ度 4.5点
現在、2805件のレビューが投稿されています。
![BEAUCOUP FISH-SUPER DELUXE [輸入盤][2LP][アナログ] - アンダー](https://www.universal-music.co.jp/underworld/wp-content/uploads/sites/1203/2024/09/uw1200-01.jpg)